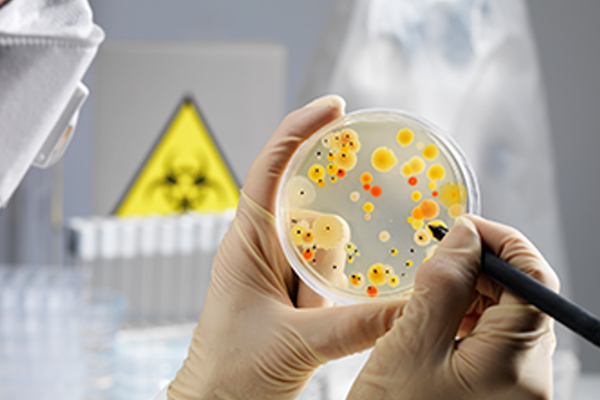

Check your health and stay tension free !
The Services can be availed by individuals as well as corporate business for their staffs and employees with free on-site sample collection. Considering the important of accuracy in diagnostic testing and patient outcomes, we deploy high-end medical tools, technology, and techniques that ensure flawless and accurate report every time.

PACKAGES
Best Packages
CATEGORIES
Popular Tests

Liver Profile

Diabetes

Lipid Profile

Thyroid Profile

Kidney Function Test
TESTS
All Tests
Cholesterol - Total
13% OFF
280
320
HbA1c (Glycated Haemoglobin)
9% OFF
499
549
Parameters Included
SARS-CoV-2 (COVID 19) RT PCR
64% OFF
500
1400
Parameters Included
WHY CHOOSE US
Why Patients Choose Our Center

COMFORT
Sample collection at your doorstep at your convenient time.

QUALITY
We offer quality and hassle-free pathology lab testing services.

AVAILABILITY
Talk to us for any queries and we will help you to pick the best option.

AFFORDABILITY
Tests and packages at affordable prices tailored just for you.
WHAT WE OFFER
Our Services

Doctor Consultancy

Become Business Partner

Corporate Camps

Corporate Camps
DEPARTMENTS
Our Departments

Hematology & Coagulation

Clinical BioChemistry

Immunology

Serology
Microbiology

Molecular Biology

Histopathology & Cytology
DOCTOR CONSULTATION
Meet Our Doctor

Dr. Akhilesh
MBBS, MD(PAEDIATRICS) Consultant Paediatrician & Neonatologist
Dr. B. Vijay Kumar
MBBS, MD(GEN MEDICINE), DM(CARDIOLOGY) Consultant Cardiologist
Dr. D. Krishna Murthy
MBBS, DNB(GEN MEDICINE) Consultant Physician & Diabetologist
OUR CLIENTS
Trusted by corporate clients





TESTIMONIALS
What our clients say
WE LOVE TO SHARE THIS
Blogs
WHAT MAKES US PROUD
Certifications











